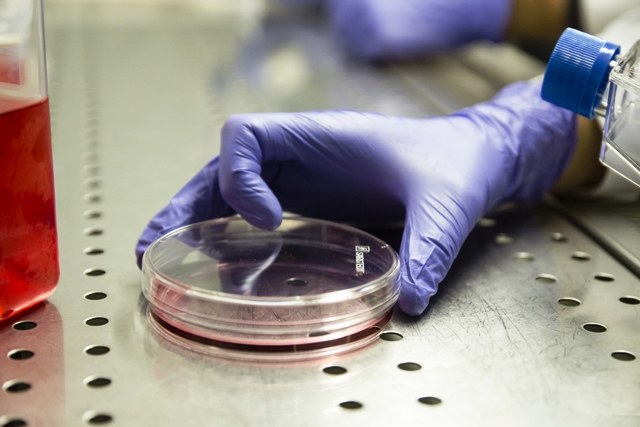

Un nuovo approccio per mettere a punto farmaci antitumorali “super-intelligenti” che agiscono utilizzando il principio della “letalità sintetica”. È il risultato di uno studio, da poco pubblicato sulla rivista ACS Chemical Biology, nato da una collaborazione tra i dipartimenti di Farmacia e Biotecnologie e di Medicina Specialistica Diagnostica e Sperimentale dell’Università di Bologna, l’Istituto Italiano di Tecnologia, l’Istituto Oncologico Europeo e TES Pharma.
La “letalità sintetica” è un meccanismo che, sfruttando le differenze genetiche fra cellule tumorali e cellule sane, permette di uccidere in maniera mirata soltanto le cellule malate, risparmiando le altre. Un principio, questo, con grandi potenzialità, che viene già utilizzato in alcune terapie antitumorali, ad esempio quella che coinvolge pazienti oncologici con mutazioni del gene BRCA2.
Un difetto nel gene BRCA2 è spesso associato allo sviluppo di tumori al seno o alle ovaie. Utilizzando sostanze che inibiscono un enzima, chiamato PARP, addetto alla riparazione del DNA, la terapia basata sulla letalità sintetica va a colpire solo le cellule “difettose”, quelle cioè nelle quali il gene BRCA2 risulta mutato.
Non tutti i pazienti oncologici presentano però questa mutazione. E ciò ha reso fino ad oggi relativamente ridotte le possibilità di applicazione della letalità sintetica.
Il nuovo studio pubblicato su ACS Chemical Biology punta a superare questo scoglio grazie ad un approccio innovativo che permetterà di ampliare il raggio di applicazione della terapia. Utilizzando alcune molecole appositamente selezionate e ottimizzate, i ricercatori sono per la prima volta riusciti a compromettere chimicamente il funzionamento del gene BRCA2. In questo modo, sarà possibile utilizzare farmaci PARP inibitori anche sui pazienti nei quali il gene BRCA2 è pienamente funzionante.
Per raggiungere questo risultato, il gruppo di ricerca ha identificato, grazie a programmi di screening virtuale, circa novanta molecole candidate, prima valutate per la loro attività inibitoria e successivamente ottimizzate con procedure sintetiche sviluppate ad hoc.
Il composto che ha mostrato i risultati migliori è stato quindi selezionato per ulteriori studi, in associazione con Olaparib, un farmaco PARP inibitore utilizzato già dal 2014. E la risposta è stata positiva: dai dati raccolti è infatti emerso che l’associazione tra i due composti agisce in maniera sinergica, dando vita ad una letalità sintetica farmacologicamente indotta.